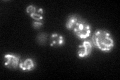
YGR207C

View description
Protein that interacts with frataxin (Yfh1p); putative homolog of mammalian electron transfer flavoprotein complex subunit ETF-beta; authentic, non-tagged protein is detected in highly purified mitochondria in high-throughput studies
Localization:
Intensity:
Fold change:
Significance:
-
C’ GFP library in SD

mitochondria79.86 -
N' NOP1pr-GFP in SD

N/A0 -
N' TEF2pr-mCherry in SD

N/A0 -
N' NATIVEpr-GFP in SD

N/A0 -
N' TEF2pr-VC and Cyto-VN in SD

N/A0 -
C’ GFP library in SD+DTT

mitochondria87.171.09No -
C’ GFP library in SD+H2O2

mitochondria94.111.17No -
C’ GFP library in Starvation Media
mitochondria124.491.55Yes -
C’ GFP library on the background of Pup2-DaMP

mitochondria -
C’ GFP library on the background of CCT mutant

mitochondria79.4170.994427No
